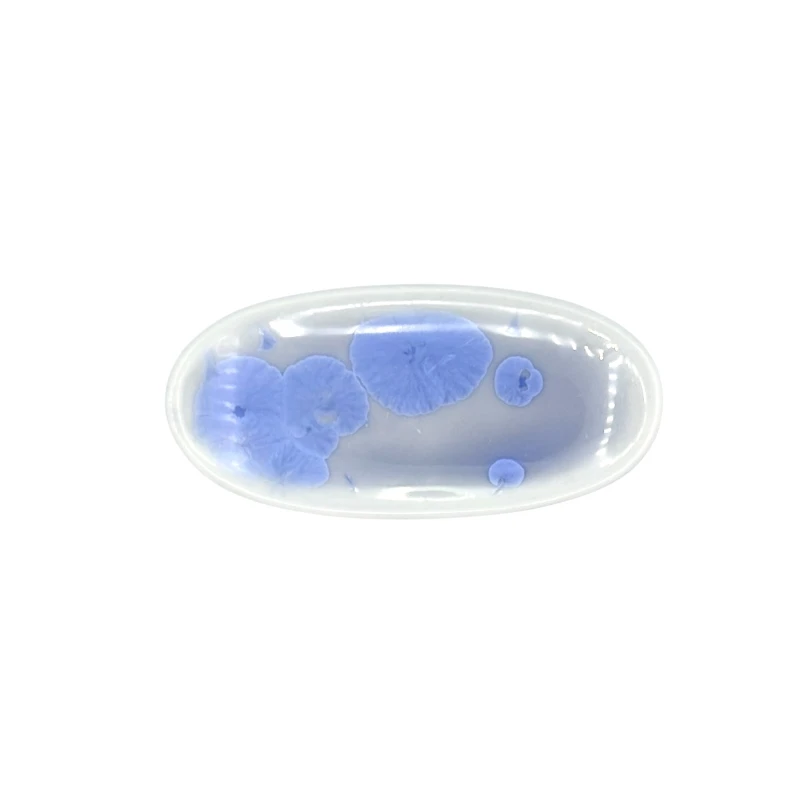
京焼　箸置　花結晶　楕円　青

京焼 箸置 花結晶 楕円 5個セット
商品番号CR-CE-KTKM-269
花が咲いたような結晶釉が美しい箸置です。上品な淡い色合いが、柔らかい印象を与えてくれます。
名入れについて

商品をカートに入れる前に「名入れする」のチェックボックスにチェックを入れて、カートへお入れください。
次のページで表示される名入れフォームで名入れ文字他をご入力下さい。
(異なる文字の名入れをご希望の場合は一つずつカートに入れていただき、それぞれ名入れフォームをご入力下さい)
一膳につき400円+税(専用の機械による彫刻名入れ)
作成期間を約1週間ほど頂いております。
※珊瑚箸シリーズのみ一膳につき1,200円+税
(レーザーを使用した名入れ)
【名入れの例】
- 感謝の言葉を、お箸に乗せて
- ご結婚やお誕生日など特別な日の贈り物として
- ご卒業・退職記念などに
- ご家族でお揃いの箸に名前を入れて
- 部活動やサークルの仲間同士で
- 飲食店など、常連のお客様に
ギフト包装について
お箸のギフト用のラッピングとして紙箱と桐箱がお選びいただけます。また、ご家族用として5膳まで入る紙箱もご用意しております。
(お子様食器に関してはギフト用・ご自宅用問わず、紙箱(無料)に入れてのお届けとなります(ギフト用はその上から包装紙にてラッピング)) お箸用の無料のラッピングは、箸袋に入れるタイプのものになります。
お箸用のギフトボックスをご注文いただいた方は、¥440-(税別)
でさらに風呂敷でのラッピングもご指定いただけます。日本の伝統的な贈り物のスタイルで、お箸のプレゼントにぴったりな包装です。
のしについて


御希望により、掛紙をお付けいたします。
用途に応じて表題、お名前(贈り主)の文字をお入れいたします。
【のしの種類】
- 御礼(蝶結び)
- 御祝(蝶結び)
- 寿・結婚祝(結び切り)
- 御出産御祝 (蝶結び)
- 内祝(蝶結び)
- 御見舞(結び切り)
- 快気祝(結び切り)
- 記念品 (蝶結び)
- 志
- その他
- 無し
- ご希望により、のしに名入れいたします。
- のしは箱包装の場合のみサービスとなります。
メッセージカードについて

ギフト用として紙箱または桐箱をご注文いただいたお客様には、以下のような箸渡しのメッセージカードを箱に同封していただくことが可能です。
お祝いや感謝の気持ちを伝えるものから気軽なプレゼントまで、さまざまなシチュエーションに対応可能です。
【メッセージカードの種類】
- ありがとうの箸渡し
- 笑顔の箸渡し
- 人と人との箸渡し
- まごころの箸渡し
- 幸せの箸渡し
- ありがとうございます
- おめでとうございます
- ご出産おめでとうございます
- お父さんありがとう
- お母さんありがとう
- お父さんお母さんありがとう
- おじいちゃんありがとう
- おばあちゃんありがとう
- おじいちゃんおばあちゃんありがとう
- お誕生日おめでとうございます
- 無地
(無地をご選択いただいた場合は、包装内に同封せず小袋が別途付きます)



 ログイン
ログイン カート
カート お気に入り
お気に入り